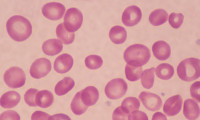

ІНТЕРВ’Ю
-
Комунальне підприємство “Дніпропетровська обласна клінічна лікарня імені І.І. Мечникова” Дніпропетровської обласної ради” є провідним закладом охорони...
-
Богдан Джуран – керуючий партнер Хірургічного центру країни ДІЄВО (ТМ), уролог-хірург, доцент, кандидат медичних наук.
-
КНП “Чернігівський медичний центр сучасної онкології” ЧОР – це високоспеціалізований заклад охорони здоров’я, який надає онкологічну допомогу мешканця...
-
Медицина на передовій здоров’я: героїчний 2023-й пропонуємо публікацію вашого інтерв’ю (безкоштовно)
-
25.11.2023, ТОВ «ІНФОРМАЦІЙНІ ТЕХНОЛОГІЇ В МЕДИЦИНІ» виповнилося 8 років.
-
Попри думки, що зайва вага про самоприйняття себе та оточуючих, це також і ризики для здоров’я.
-
Якщо раніше ми розглядали варіант коли внаслідок настання похолодань знижується рівень вітаміну D в організмі.
-
Осінньо-зимовий період це завжди про зменшення сонячних променів та появі необхідності у контролю рівня вітаміну D (сонячного вітаміну).
-
Нам знайоме таке порушення як «анемія», коли в організмі виникає низький рівень еритроцитів.
-
У вас виникає непереборне бажання з’їсти щось солодке, якщо ви не голодні?
Рекомендовані клініки
-
ПоліклінікаУкраїна, c. Сміла
-
Центр первинної медико-санітарної допомоги
-
Лікарня
-
Лікарня
-
Амбулаторія загальної практики сімейної медицини
ПУБЛІКАЦІЇ КЛІНІК